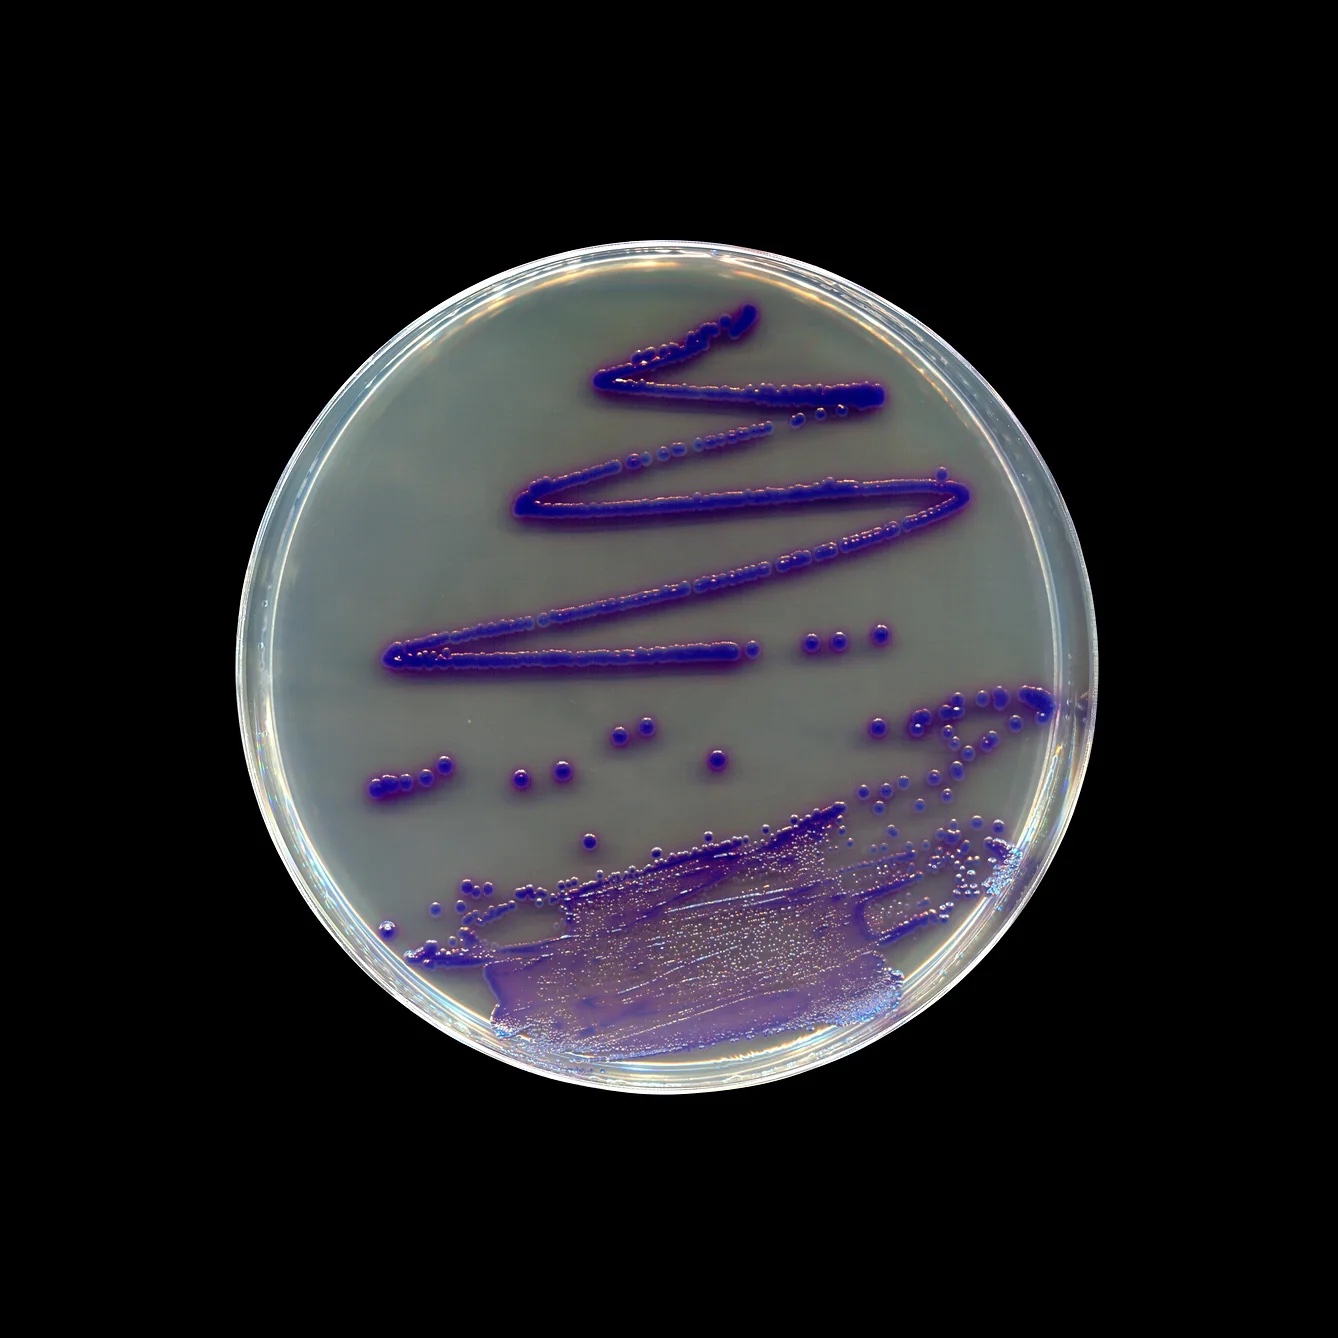
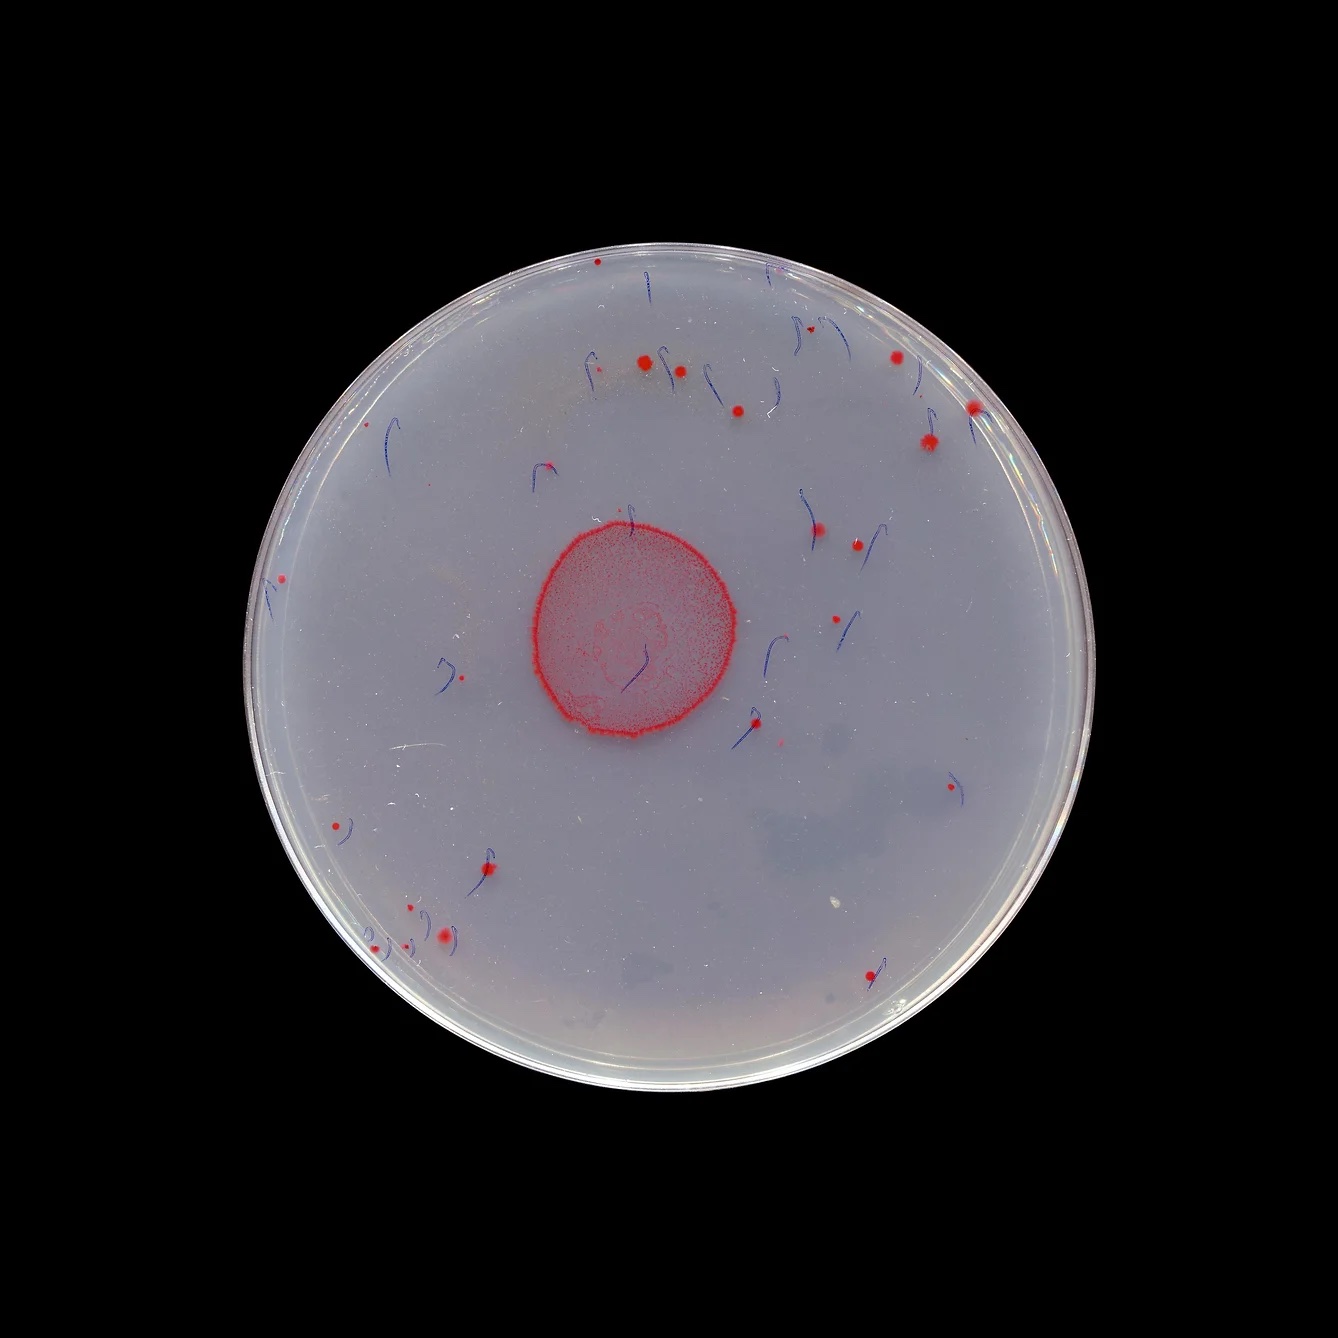

ccckkkk
b. 1976, Aotearoa New Zealand. Lives and works Melbourne/Naarm, Australia
Dane
A
xxxxxx
DANE MITCHELL
b. 1976, Aotearoa New Zealand. Lives and works Melbourne/Naarm, Australia
Dane Mitchell’s work is shaped by a profound exploration of dualities — the tangible and intangible, suppression and expansiveness, presence and absence. It is a multi-layered investigation into the complexities of perception and of the interplay between what is seen and what remains unseen.
Mitchell probes the nature of containment, examining entities like museums, encyclopedias, language, and material enclosures. Simultaneously, he explores the elusive and what is ultimately uncontainable - encompassing vapors, forces, transmissions, extinctions and contagions.
He has presented solo exhibitions at prestigious institutions such as the Mori Art Museum in Tokyo, Daadgalerie in Berlin, and Te Papa in Wellington whilst his participation in numerous biennales, including Venice, Sydney, and Gwangju highlight the international recognition of his practice. He is currently a studio resident at Gertrude Contemporary, Melbourne.
Dane Mitchell is represented nationally in Australia by The Renshaws.
Dane
A
xxxxxx